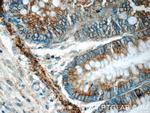
ARAP3 Antibody in Immunohistochemistry (Paraffin) (IHC (P))

Search
Proteintech
ARAP3 Polyclonal Antibody
{{$productOrderCtrl.translations['antibody.pdp.commerceCard.promotion.promotions']}}
{{$productOrderCtrl.translations['antibody.pdp.commerceCard.promotion.viewpromo']}}
{{$productOrderCtrl.translations['antibody.pdp.commerceCard.promotion.promocode']}}: {{promo.promoCode}} {{promo.promoTitle}} {{promo.promoDescription}}. {{$productOrderCtrl.translations['antibody.pdp.commerceCard.promotion.learnmore']}}
产品信息
22578-1-AP
种属反应
宿主/亚型
分类
类型
抗原
偶联物
形式
浓度
规格
纯化类型
保存液
内含物
保存条件
运输条件
产品详细信息
Immunogen sequence: PRVGLLRCR EEPPRLLGSR FQERFFLLRG RCLLLLKEKK SSKPEREWPL EGAKVYLGIR KKLKPPTPWG FTLILEKMHL YLSCTDEDEM WDWTTSILKA QHDDQQPVVL RRHSSSDLAR QKFGTMPLLP IRGDDSGATL LSANQTLRRL HNRRTLSMFF PMKSSQGSVE EQEELEEPVY EEPVYEEVGA FPELIQDTST SFSTTREWTV KPENPLTSQK SLDQPFLSKS STLGQEERPP EPPPGPPSKS SPQARGSLEE QLLQELSSLI LRKGETTAGL GSPSQPTSPQ SPSPTGLPTQ TPGFPTQPPC TSSPPSSQPL T (1225-1544 aa encoded by BC009968)
靶标信息
Ubiquitin is a conserved 76 amino acid polypeptide and can affect proteasomal degradation of the protein it is bound to, or mediate interactions with other proteins related to post-translational modifications. The degradation of cellular regulatory proteins by the Uubiquitin pathway is important as it controls the cellular growth and proliferation. Ubiquitin-dependent proteolysis occurs after a covalent attachment of the peptide to a lysine residue of a protein, which involves three enzymatic reactions: E1, E2 and E3. The first reaction involves ubiquitin-activating enzyme. The third reaction uses enzyme ubiquitin ligase (E3) to transfer the activated ubiquitin from E2 to a lysine residue on a protein, or directly transfers the ubiquitin from E2 to the substrate.
仅用于科研。不用于诊断过程。未经明确授权不得转售。
篇参考文献 (0)
生物信息学
蛋白别名: Arf and Rho GAP adapter protein 3; Arf-GAP with Rho-GAP domain, ANK repeat and PH domain-containing protein 3; ARF-GAP, RHO-GAP, ankyrin repeat and plekstrin homology domains-containing protein 3; centaurin; Centaurin-delta-3; Cnt-d3; FLJ21065; phosphoinositide binding protein; PtdIns(3,4,5)P3-binding protein; unnamed protein product
基因别名: ARAP3; CENTD3; DRAG1
UniProt ID: (Human) Q8WWN8
Entrez Gene ID: (Human) 64411